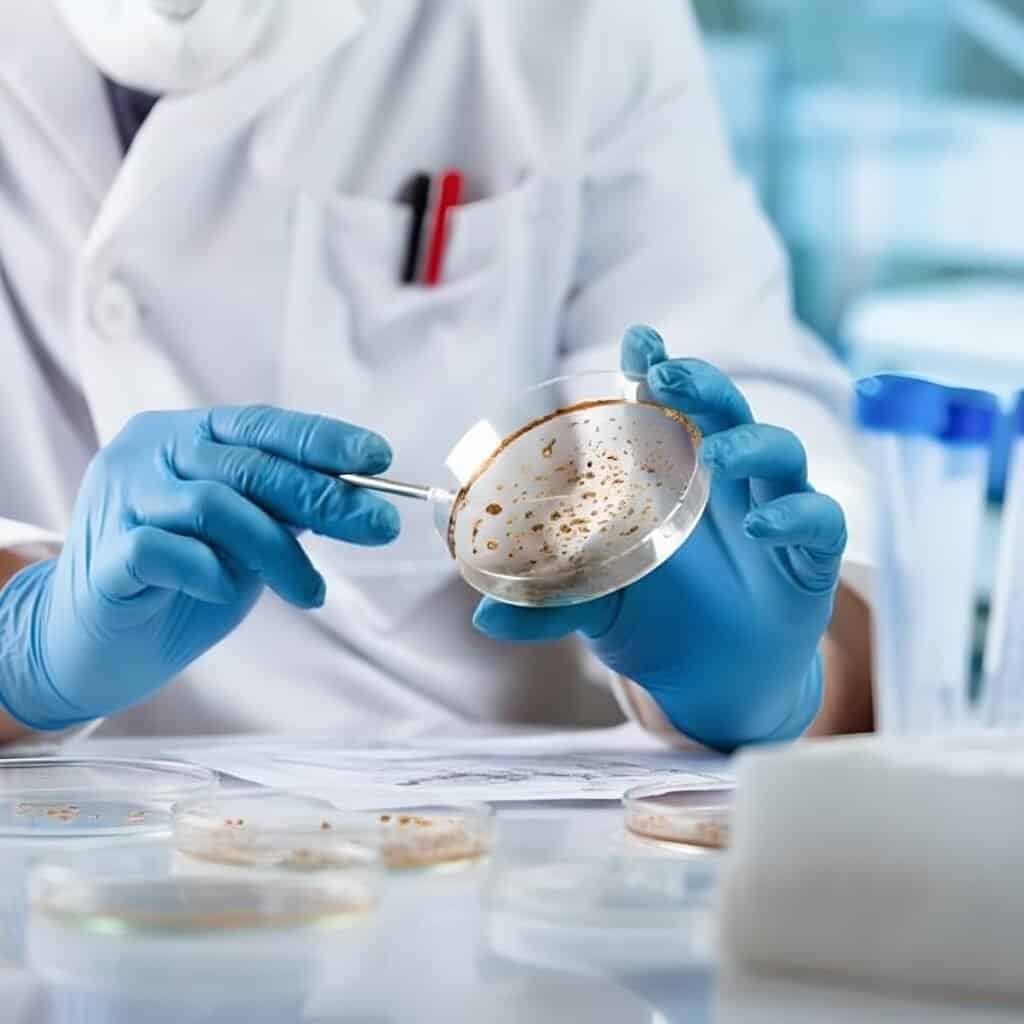

Producător de medicamente din România.
Arena Group
Arena Group este o societate românească recunoscută pentru excelență și inovație în producția farmaceutică.
Cu o tradiție solidă și standarde înalte de calitate, ne-am dedicat transformării experienței în grijă autentică pentru sănătate.
250
produse
in portofoliu
20
produse
unic producător
30+
ani
experiența

Laborator propriu
din 1993 prezenți pe piață
Producție locală
Peste 30 de produse dezvoltate.
Portofoliu de produse
Portofoliul Arena Group include medicamente și suplimente dezvoltate și fabricate local, adaptate cerințelor pieței și reglementărilor în vigoare.
RX
Medicamente eliberate pe bază de prescripție medicală.
OTC
Medicamente eliberate
fără prescripție.Suplimente alimentare
Produse pentru completarea dietei. Nu sunt medicamente.
Testare și control al calității.
Laborator propriu
Arena Group dispune de un laborator propriu, unde produsele sunt testate riguros pentru a asigura conformitatea cu standardele farmaceutice, siguranța utilizatorilor și eficiența produsului.
Certificate de Calitate
Toate produsele respectă standardele naționale și internaționale de calitate.
Logistică Rapidă
Sistem de distribuție eficient pe întreg teritoriul țării.
Suport Dedicat
Echipă profesionistă disponibilă pentru consultanță și asistență.
Beneficii pentru parteneri
Servicii oferite
Capacitate de producție extinsă, laborator propriu și sistem logistic eficient. Suntem partenerul de încredere pentru farmacii, distribuitori și rețele de retail.